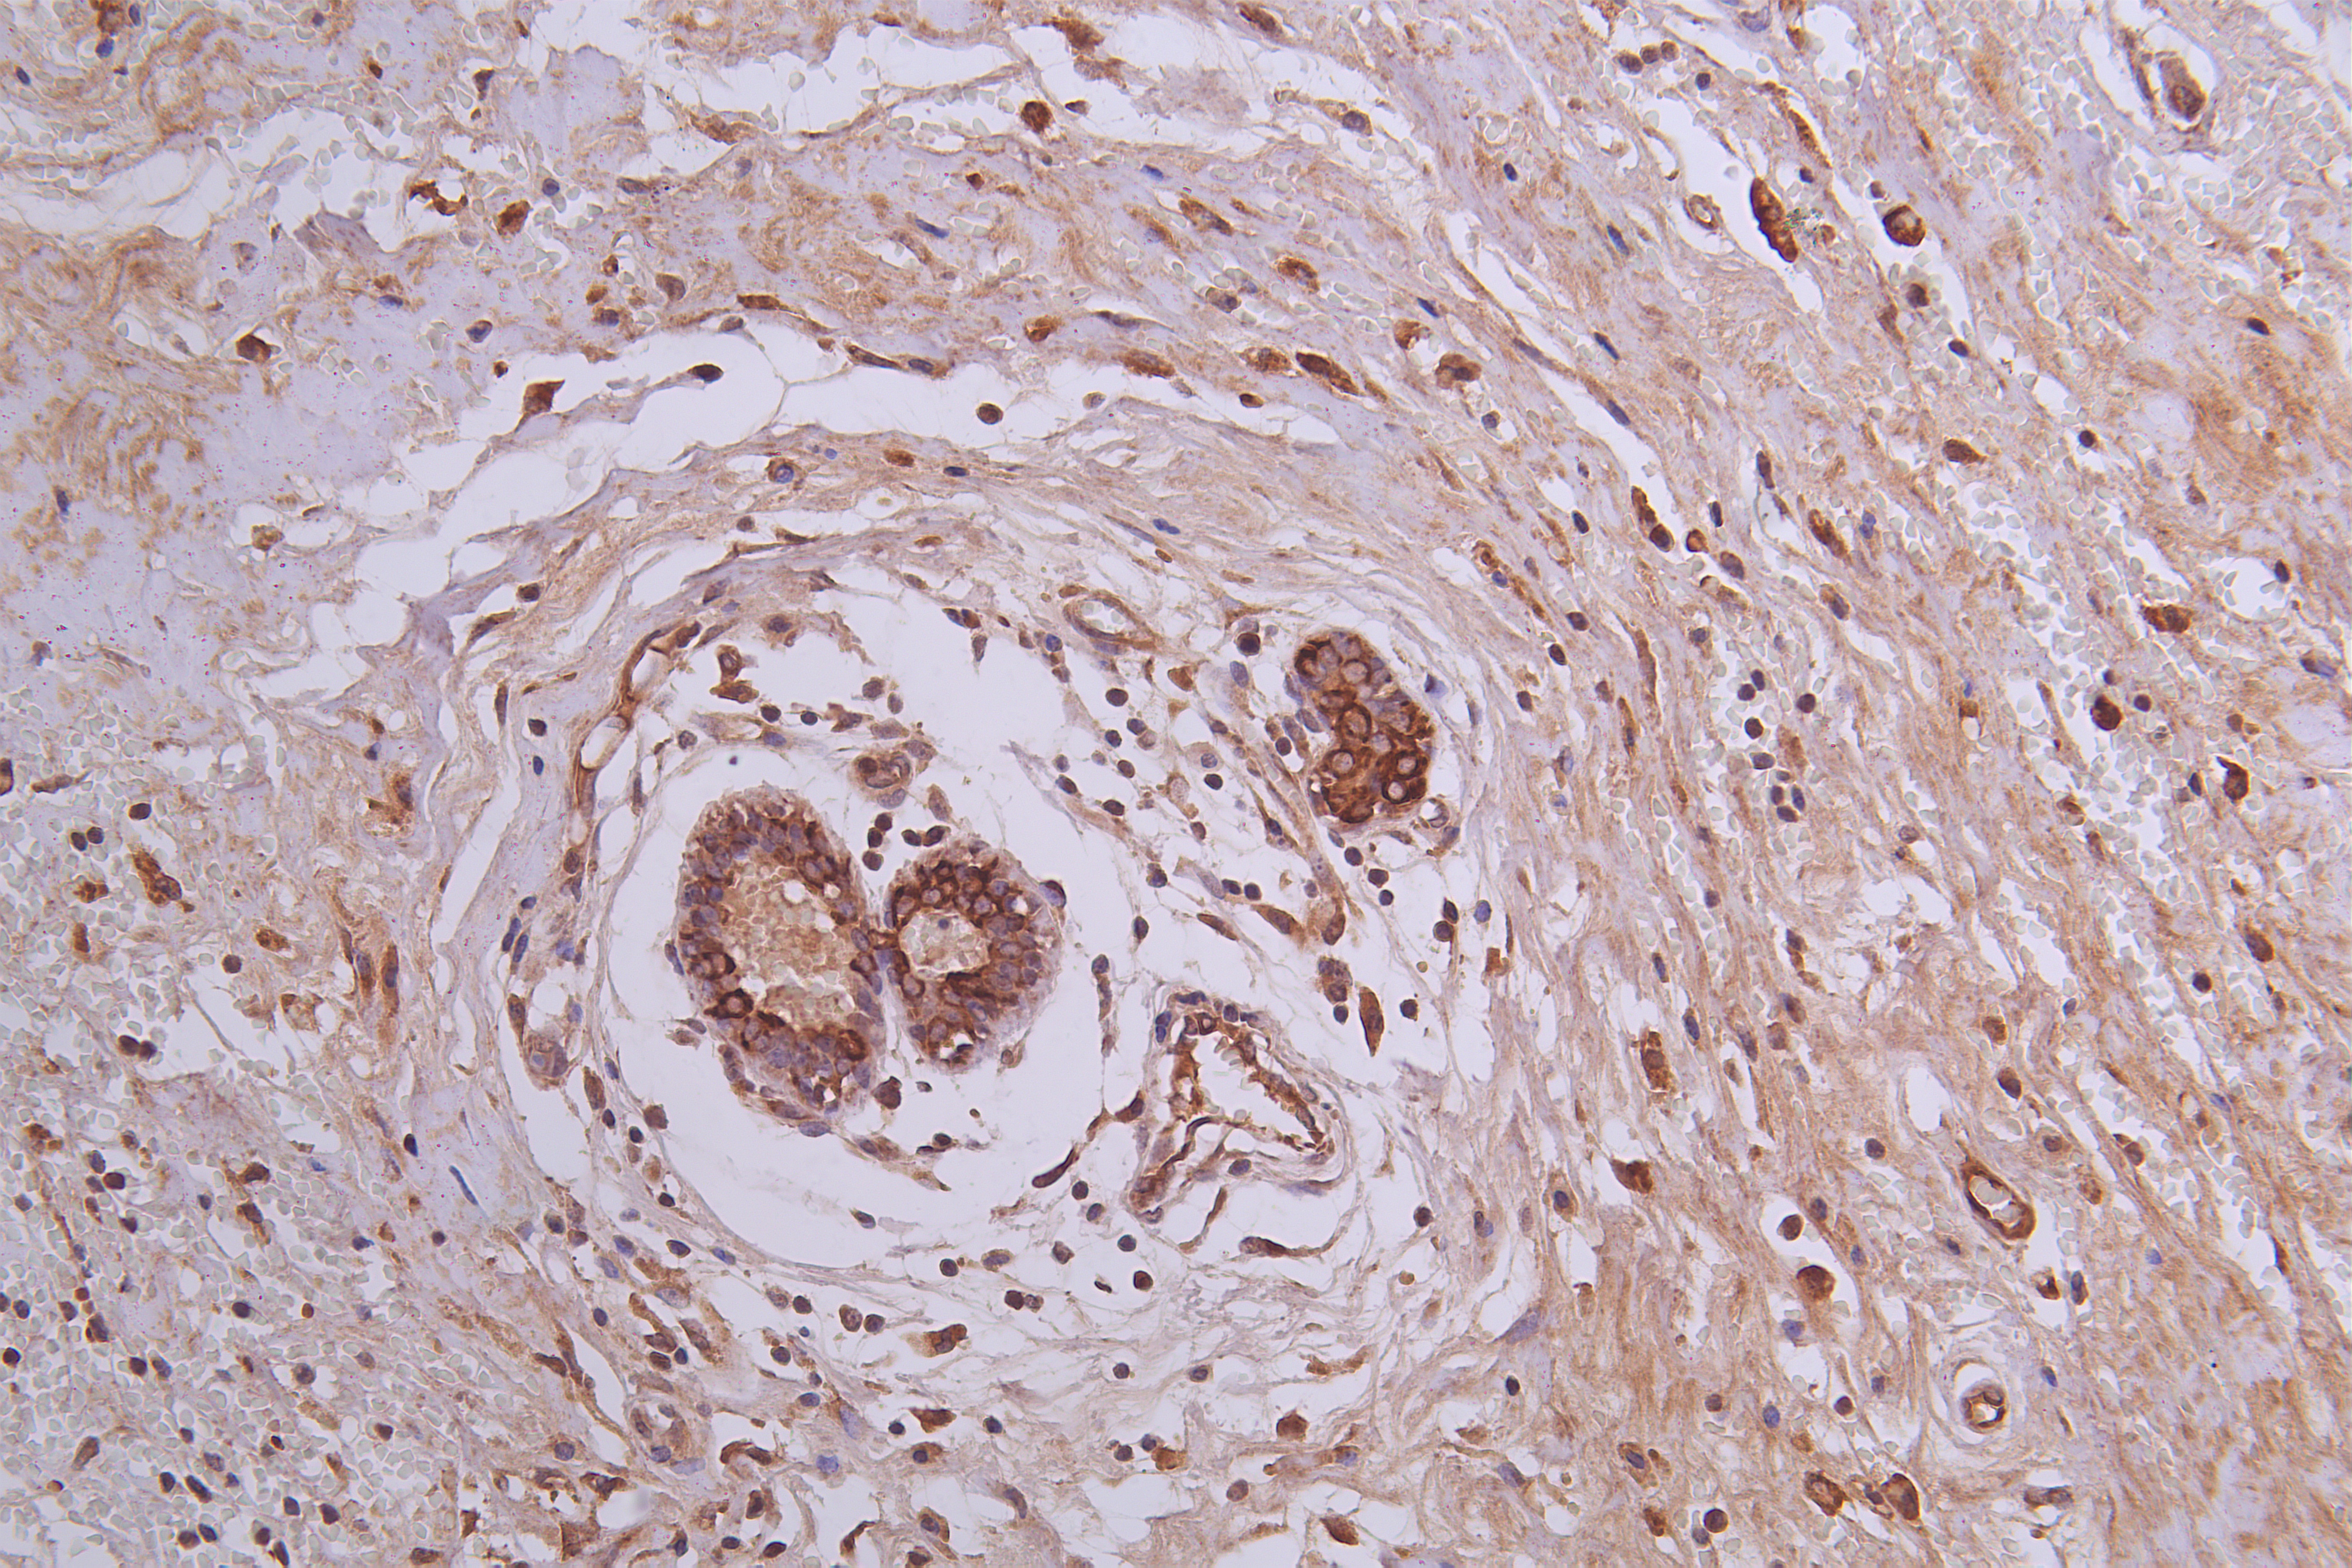

MTCH1 Antibody
-
中文名稱:MTCH1兔多克隆抗體
-
貨號:CSB-PA868369ESR1HU
-
規(guī)格:¥440
-
圖片:
-
Western Blot
Positive WB detected in: MCF7 whole cell lysate(20μg), HepG2 whole cell lysate(20μg), 293T whole cell lysate(20μg), A431 whole cell lysate(20μg), U251 whole cell lysate(20μg), Hela whole cell lysate(20μg), Mouse brain tissue lysate(20μg), Rat brain tissue lysate(20μg)
All lanes: MTCH1 antibody at 1:500
Secondary
Goat polyclonal to rabbit IgG at 1/40000 dilution
Predicted band size: 42,40,20 kDa
Observed band size: 42 kDa
Exposure time: 120s -
Immunohistochemistry of paraffin-embedded human Breast cancer tissue using CSB-PA868369ESR1HU at dilution of 1:50
-
-
其他:
產(chǎn)品詳情
-
產(chǎn)品名稱:Rabbit anti-Homo sapiens (Human) MTCH1 Polyclonal antibody
-
Uniprot No.:
-
基因名:
-
別名:MTCH1; PSAP; CGI-64; UNQ1871/PRO4314; Mitochondrial carrier homolog 1; Presenilin-associated protein
-
宿主:Rabbit
-
反應(yīng)種屬:Human, Mouse, Rat
-
免疫原:Recombinant Human Mitochondrial carrier homolog 1 protein (100-250AA)
-
免疫原種屬:Homo sapiens (Human)
-
標(biāo)記方式:Non-conjugated
-
克隆類型:Polyclonal
-
抗體亞型:IgG
-
純化方式:Antigen Affinity Purified
-
濃度:It differs from different batches. Please contact us to confirm it.
-
保存緩沖液:Preservative: Preservative: 0.03% Proclin 300
Constituents: 50% Glycerol, 0.01M PBS, pH 7.4 -
產(chǎn)品提供形式:Liquid
-
應(yīng)用范圍:ELISA, WB, IHC
-
推薦稀釋比:
Application Recommended Dilution WB 1:500-1:2000 IHC 1:20-1:200 -
Protocols:
-
儲存條件:Upon receipt, store at -20°C or -80°C. Avoid repeated freeze.
-
貨期:Basically, we can dispatch the products out in 1-3 working days after receiving your orders. Delivery time maybe differs from different purchasing way or location, please kindly consult your local distributors for specific delivery time.
-
用途:For Research Use Only. Not for use in diagnostic or therapeutic procedures.
相關(guān)產(chǎn)品
靶點(diǎn)詳情
-
功能:Potential mitochondrial transporter. May play a role in apoptosis.
-
基因功能參考文獻(xiàn):
- Data suggest that the transmembrane domain of Bcl-XL could be involved in protein oligomerization, shown here with presenilin-1 associated protein. PMID: 21856303
- Results indicate that EGR-1 is a transcriptional regulator of MTCH1 and give some clues about the cellular processes in which MTCH1 might participate. PMID: 26692143
- Mtch1 antibody positive neuro-Bechet's disease patients had more attacks, increased disability and lower serum nucleosome levels. PMID: 24035008
- Data indicate that the formation of cytochrome c-Apaf-1 apoptosome and the presence of Smac are absolutely required for PSAP-induced apoptosis. PMID: 23207240
- Strong candidate gene for mitochondrial disease, based on recessive mutations detected in infantile patients PMID: 22277967
- mitochondrial localization and proapoptotic activity of PSAP suggest that it is an important regulator of apoptosis PMID: 12377771
- PSAP has two proapoptotic isoforms generated by alternative splicing, and both proteins are imported into the mitochondrial outer membrane using multiple internal targeting signals, and both contain two proapoptotic domains. PMID: 17670888
- Data show that all PSAP splicing isoforms are localized in the mitochondria and are pro-apoptotic. PMID: 18291114
顯示更多
收起更多
-
亞細(xì)胞定位:Mitochondrion outer membrane; Multi-pass membrane protein.
-
蛋白家族:Mitochondrial carrier (TC 2.A.29) family
-
組織特異性:Widely expressed with a predominant expression in brain.
-
數(shù)據(jù)庫鏈接:
Most popular with customers
-
-
YWHAB Recombinant Monoclonal Antibody
Applications: ELISA, WB, IHC, IF, FC
Species Reactivity: Human, Mouse, Rat
-
Phospho-YAP1 (S127) Recombinant Monoclonal Antibody
Applications: ELISA, WB, IHC
Species Reactivity: Human
-
-
-
-
-